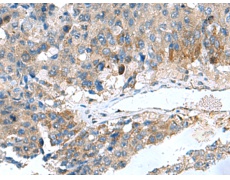
一抗

中文名稱: 兔抗HSD11B1多克隆抗體
英文名稱: Anti-HSD11B1 rabbit polyclonal antibody
宿 主: Rabbit
反應種屬: Human
技術規(guī)格
|
Background: |
The protein encoded by this gene is a microsomal enzyme that catalyzes the conversion of the stress hormone cortisol to the inactive metabolite cortisone. In addition, the encoded protein can catalyze the reverse reaction, the conversion of cortisone to cortisol. Too much cortisol can lead to central obesity, and a particular variation in this gene has been associated with obesity and insulin resistance in children. Mutations in this gene and H6PD (hexose-6-phosphate dehydrogenase (glucose 1-dehydrogenase)) are the cause of cortisone reductase deficiency. Alternate splicing results in multiple transcript variants encoding the same protein. |
|
Applications: |
ELISA, IHC |
|
Name of antibody: |
HSD11B1 |
|
Immunogen: |
Fusion protein of human HSD11B1 |
|
Full name: |
hydroxysteroid 11-beta dehydrogenase 1 |
|
Synonyms: |
HDL; 11-DH; HSD11; HSD11B; HSD11L; CORTRD2; SDR26C1; 11-beta-HSD1 |
|
SwissProt: |
P28845 |
|
ELISA Recommended dilution: |
5000-10000 |
|
IHC positive control: |
Human colorectal cancer and Human liver cancer |
|
IHC Recommend dilution: |
50-200 |




 購物車
購物車 幫助
幫助
 021-54845833/15800441009
021-54845833/15800441009